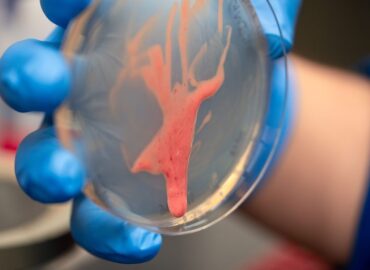
1670 Ralstonia Solanacearum Bakterija Sukelianti Augalų Infark

Ralstonia solanacearum – pavojingas augalų priešas
Bakterija Ralstonia solanacearum gali ilgai išlikti neaktyvi drėgnoje dirvoje, tačiau staiga sukelti augalų, tokių kaip pomidorai ar bulvės, žūtį per kelias dienas. Mokslininkai iš Kalifornijos universiteto Dėvyje atskleidė, kaip šiai bakterijai tai pavyksta.
Svarbus vaidmuo – biopluoštas
Pasirodo, viską lemia bakterijos išskiriamas biopluoštas. Skirtingai nei daugelio kitų bakterijų, Ralstonia solanacearum biopluoštas yra skystas ir tekus. Tyrėjai jį apibūdina kaip „charizmatiškai atgrasų“, o darbas su juo laboratorijoje nėra malonus.
Augalų „infarkto“ mechanizmas
Biopluoštas užkemša augalų ksilėmą – vandens transportavimo sistemą. Tai sukelia augalo „uždusimą“ – procesas panašus į infarktą. Norint suprasti šį mechanizmą, mokslininkams prireikė inžinierių pagalbos.
Inžinierių indėlis
Profesorius Hari Manikantanas, tiriantis viskoelastines skysčių savybes, padėjo nustatyti, kad Ralstonia biopluoštas lengvai teka esant augalo kraujagyslių sukeliamam spaudimui. Tai leidžia bakterijoms greitai užkariauti naujas teritorijas.
Naujas testas
Tyrėjų komanda sukūrė paprastą testą: jei bakterijos auga Petri lėkštelėje ir lėkštelė pakreipiama, ar jos pradės tekėti? Tik patogeniniai štamai pasižymi šiuo „lašančiu“ elgesiu. Giminaičiai, bet nepavojingi bakterijų štamai, elgiasi kitaip.
Reikšmė mokslui
Toks atradimas biologams paaiškina, kodėl Ralstonia solanacearum yra tokia pavojinga. Fizikams tai suteikia naują sistemą sudėtingų skysčių tyrimams.